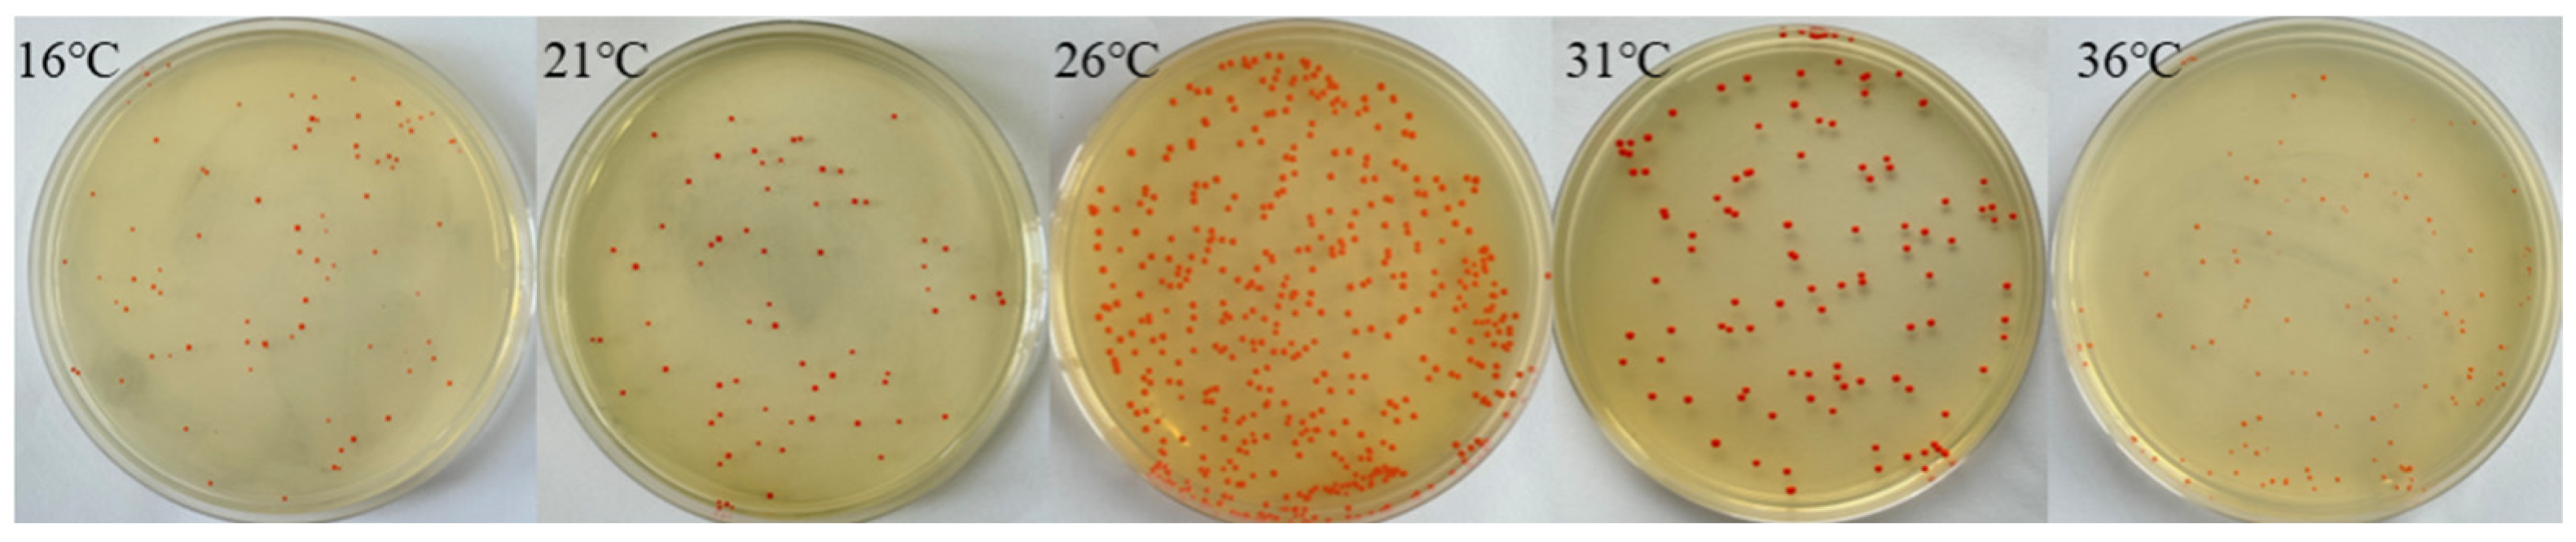
Microorganisms 13 02003 g003 Microorganisms 13 02003 g003

Identification of a Red Pigment-Producing Strain of Arthrobacter spp. and the Stability of Its Pigments
Abstract
1. Introduction
2. Materials and Methods
2.1. Materials
2.1.1. Sample Sources
2.1.2. Culture Medium
2.1.3. Data Analysis
2.2. Methods
2.2.1. Morphological Identification and Molecular Biological Identification of Strains
2.2.2. Determination of the Relative Optimal Growth Temperature and Pigment Solubility of the Strain
2.2.3. Effects of Different Single-Factor Conditions on Red Pigment Production
- Effects of different carbon sources, nitrogen sources, and inoculum amount of culture medium on pigment yield:
- Beef extract, glucose, sucrose, glycerol, and ethanol were selected as the carbon sources of the screened medium, respectively, and the rest of the components were the same. The inoculum was 2%, and the medium was incubated at 27 °C and 160 rpm for 48 h. Each temperature gradient was repeated three times. The Optical Density (OD) value was measured, and the colour value of red pigment was calculated to compare the effect of each carbon source on the red pigment yield.Peptone, yeast extract, (NH4)2SO4, and NH4Cl were selected as the nitrogen source of the screened medium, and the rest of the components were the same. The same method was used as in the carbon source experiment.The selected carbon sources and nitrogen sources were used as the medium components, and the rest of the components were unchanged. Six different strains of 1%, 2%, 3%, 4%, 5%, and 6% were selected as inoculum and cultured under the same conditions, respectively. Each temperature gradient was repeated three times. The OD value was measured, the colour value of red pigment was calculated, and the inoculum quantity was selected.
- Effects of different pH, temperature, and rotational speed on pigment yield:The selected carbon and nitrogen sources were used as the medium components, while the rest of the components remained unchanged. The pH of the medium was adjusted to 5, 6, 7, 8, and 9, respectively, and cultured under the same conditions with the optimal amount of bacteria. Each temperature gradient was repeated three times. The OD value was measured, the red pigment colour value was calculated, and the optimal pH value was selected for comparison.The temperature was set at 21 °C, 24 °C, 27 °C, 30 °C, and 33 °C, and the operation was the same as above.The rotational speed was set at 100 rpm, 130 rpm, 160 rpm, 190 rpm, and 220 rpm, and the operation was as above.
2.2.4. Optimisation of Response Surface Conditions
2.2.5. Effect of Light, Temperature, pH, Oxidants and Metal Ions on the Stability of Red Pigments
3. Results
3.1. Morphological Characteristics and Molecular Biological Identification of Red Pigment-Producing Strains
3.2. Determination of the Relative Optimum Growth Temperature and Pigment Solubility of Red Pigment-Producing Strains
3.3. Effect of Single-Factor Conditions on Pigment Yield
3.3.1. Effects of Medium Carbon Source, Nitrogen Source, and the Amount of Bacteria Received on Pigment Yield
3.3.2. Effect of pH, Temperature, and Rotational Speed on Pigment Production
3.4. Response Surface Test Optimisation Results
3.4.1. Model Establishment and Significance Analysis
0.0004BC − 0.0212A2 − 0.1646 B2 − 0.0002C2
3.4.2. Response Surface Analysis
3.5. Effect of Light, Temperature, pH, Oxidants, and Metal Ions on the Stability of Red Pigments
4. Discussion
Author Contributions
Funding
Institutional Review Board Statement
Informed Consent Statement
Data Availability Statement
Conflicts of Interest
References
- Yu, X.; Zhang, W.; Wu, Y.; Chen, T.; Liu, G. Production Mechanism and Biological Activity of Microbial Pigments. Acta Microbiol. Sin. 2022, 62, 1231–1246. [Google Scholar]
- Osman, M.Y.; Sharaf, I.A.; Osman, H.M.Y.; El-Khouly, Z.A.; Ahmed, E.I. Synthetic Organic Food Colouring Agents and Their Degraded Products: Effects on Human and Rat Cholinesterases. Br. J. Biomed. Sci. 2004, 61, 128–132. [Google Scholar] [CrossRef]
- Manikprabhu, D.; Lingappa, K. γ Actinorhodin a Natural and Attorney Source for Synthetic Dye to Detect Acid Production of Fungi. Saudi J. Biol. Sci. 2013, 20, 163–168. [Google Scholar] [CrossRef] [PubMed]
- Swami, S.B.; Ghgare, S.N.; Swami, S.S.; Shinde, K.J.; Kalse, S.B.; Pardeshi, I.L. Natural Pigments from Plant Sources: A Review. Pharma Innov. J. 2020, 9, 566–574. [Google Scholar]
- Degot, P.; Huber, V.; Touraud, D.; Kunz, W. Curcumin Extracts from Curcuma Longa — Improvement of Concentration, Purity, and Stability in Food-Approved and Water-Soluble Surfactant-Free Microemulsions. Food Chem. 2021, 339, 128140. [Google Scholar] [CrossRef] [PubMed]
- Cheng, L. Characteristics, Application, Safety Evaluation and Safety Control of Natural Food Pigment. Food Sci. 2012, 33, 399–404. [Google Scholar]
- Xu, S.; Gao, S.; An, Y. Research Progress of Engineering Microbial Cell Factories for Pigment Production. Biotechnol. Adv. 2023, 65, 108150. [Google Scholar] [CrossRef]
- Singh, T.; Pandey, V.K.; Dash, K.K.; Zanwar, S.; Singh, R. Natural Bio-Colorant and Pigments: Sources and Applications in Food Processing. J. Agric. Food Res. 2023, 12, 100628. [Google Scholar] [CrossRef]
- Rather, L.J.; Mir, S.S.; Ganie, S.A.; Shahid-ul-Islam; Li, Q. Research Progress, Challenges, and Perspectives in Microbial Pigment Production for Industrial Applications — A Review. Dyes Pigment. 2023, 210, 110989. [Google Scholar] [CrossRef]
- Moccia, F.; Martín, M.Á.; Ramos, S.; Goya, L.; Marzorati, S.; DellaGreca, M.; Panzella, L.; Napolitano, A. A New Cyanine from Oxidative Coupling of Chlorogenic Acid with Tryptophan: Assessment of the Potential as Red Dye for Food Coloring. Food Chem. 2021, 348, 129152. [Google Scholar] [CrossRef]
- Vareltzis, P.; Karatsioli, P.; Kazakos, I.; Menelaou, A.-M.; Parmaxi, K.; Economou, V. Optimization of the Reaction between 5-O-Caffeoylquinic Acid (5-CQA) and Tryptophan—Isolation of the Product and Its Evaluation as a Food Dye. Separations 2024, 11, 60. [Google Scholar] [CrossRef]
- Naisi, S.; Bayat, M.; Zahraei Salehi, T.; Rahimian Zarif, B.; Yahyaraeyat, R. Antimicrobial and Anti-Biofilm Effects of Carotenoid Pigment Extracted from Rhodotorula Glutinis Strain on Food-Borne Bacteria. Iran. J. Microbiol. 2023, 15, 79–88. [Google Scholar] [CrossRef] [PubMed]
- Thomsen, P.T.; Nielsen, S.R.; Borodina, I. Recent Advances in Engineering Microorganisms for the Production of Natural Food Colorants. Curr. Opin. Chem. Biol. 2024, 81, 102477. [Google Scholar] [CrossRef] [PubMed]
- Huang, X.; Gan, L.; He, Z.; Jiang, G.; He, T. Bacterial Pigments as a Promising Alternative to Synthetic Colorants: From Fundamentals to Applications. J. Microbiol. Biotechnol. 2024, 34, 2153–2165. [Google Scholar] [CrossRef]
- Wang, J.; Yang, M.; Wei, H.; Miao, W.; Li, S.; Gao, X. Probing the Effects of Multisite Mutations in the Lipoic Acid Region of the BCOADC-E2 Protein. Int. J. Mol. Sci. 2024, 25, 13677. [Google Scholar] [CrossRef]
- Li, Q.; Zhang, B.; Zhang, Y.; Hu, J.; Dai, Q. Bacterial Communities and Tetracycline Resistance Genes in the Soil-Rice Continuum upon Tetracycline Exposure. Appl. Soil Ecol. 2025, 205, 105762. [Google Scholar] [CrossRef]
- Zhai, Y.; Zhang, W.; Qian, H. Preliminary Separation and Qualitative Analysis of Carotenoids in Arthrobacter sp. Microbiol. China 2014, 41, 818–823. [Google Scholar]
- Passeri, V.; Koes, R.; Quattrocchio, F.M. New Challenges for the Design of High Value Plant Products: Stabilization of Anthocyanins in Plant Vacuoles. Front. Plant Sci. 2016, 7, 153. [Google Scholar] [CrossRef]
- Shen, N.; Ren, J.; Liu, Y.; Sun, W.; Li, Y.; Xin, H.; Cui, Y. Natural Edible Pigments: A Comprehensive Review of Resource, Chemical Classification, Biosynthesis Pathway, Separated Methods and Application. Food Chem. 2023, 403, 134422. [Google Scholar] [CrossRef]
- Barreto, J.V.d.O.; Casanova, L.M.; Junior, A.N.; Reis-Mansur, M.C.P.P.; Vermelho, A.B. Microbial Pigments: Major Groups and Industrial Applications. Microorganisms 2023, 11, 2920. [Google Scholar] [CrossRef]
- Thomsen, P.T.; Meramo, S.; Ninivaggi, L.; Pasutto, E.; Babaei, M.; Avila-Neto, P.M.; Pastor, M.C.; Sabri, P.; Rago, D.; Parekh, T.U.; et al. Beet Red Food Colourant Can Be Produced More Sustainably with Engineered Yarrowia Lipolytica. Nat. Microbiol. 2023, 8, 2290–2303. [Google Scholar] [CrossRef]
- Park, H.; Park, S.; Yang, Y.H.; Choi, K.Y. Microbial Synthesis of Violacein Pigment and Its Potential Applications. Crit. Rev. Biotechnol. 2021, 41, 879–901. [Google Scholar] [CrossRef]
- Gong, X.; Luo, H.; Wu, X.; Liu, H.; Sun, C.; Chen, S. Production of Red Pigments by a Newly Isolated Talaromyces Aurantiacus Strain with LED Stimulation for Screen Printing. Indian J. Microbiol. 2022, 62, 280–292. [Google Scholar] [CrossRef]
- Vendruscolo, F.; Luise Müller, B.; Esteves Moritz, D.; de Oliveira, D.; Schmidell, W.; Luiz Ninow, J. Thermal Stability of Natural Pigments Produced by Monascus ruber in Submerged Fermentation. Biocatal. Agric. Biotechnol. 2013, 2, 278–284. [Google Scholar] [CrossRef]
- Abdollahi, F.; Jahadi, M.; Ghavami, M. Thermal Stability of Natural Pigments Produced by Monascus Purpureus in Submerged Fermentation. Food Sci. Nutr. 2021, 9, 4855–4862. [Google Scholar] [CrossRef]
- Wang, J.; Miao, W.; Li, S.; Yang, M.; Gao, X. Effect of Nitrogen Fertilizer on the Rhizosphere and Endosphere Bacterial Communities of Rice at Different Growth Stages. Int. J. Mol. Sci. 2024, 25, 13702. [Google Scholar] [CrossRef]
- Ma, Q.-Y.; Fang, M.; Zheng, J.-H.; Ren, D.-F.; Lu, J. Optimised Extraction of β-Carotene from Spirulina Platensis and Hypoglycaemic Effect in Streptozotocin-Induced Diabetic Mice. J. Sci. Food Agric. 2016, 96, 1783–1789. [Google Scholar] [CrossRef] [PubMed]
- Agarwal, H.; Bajpai, S.; Mishra, A.; Kohli, I.; Varma, A.; Fouillaud, M.; Dufossé, L.; Joshi, N.C. Bacterial Pigments and Their Multifaceted Roles in Contemporary Biotechnology and Pharmacological Applications. Microorganisms 2023, 11, 614. [Google Scholar] [CrossRef]
- Ibrahim, W.M.; Olama, Z.A.; Abou-elela, G.M.; Ramadan, H.S.; Hegazy, G.E.; El Badan, D.E.S. Exploring the Antimicrobial, Antiviral, Antioxidant, and Antitumor Potentials of Marine Streptomyces Tunisiensis W4MT573222 Pigment Isolated from Abu-Qir Sediments, Egypt. Microb. Cell Factories 2023, 22, 94. [Google Scholar] [CrossRef]
- Nigam, P.S.; Luke, J.S. Food Additives: Production of Microbial Pigments and Their Antioxidant Properties. Curr. Opin. Food Sci. 2016, 7, 93–100. [Google Scholar] [CrossRef]
- Poorniammal, R.; Prabhu, S.; Dufossé, L.; Kannan, J. Safety Evaluation of Fungal Pigments for Food Applications. J. Fungi 2021, 7, 692. [Google Scholar] [CrossRef] [PubMed]
- Farawahida, A.H.; Palmer, J.; Flint, S. Monascus spp. and Citrinin: Identification, Selection of Monascus spp. Isolates, Occurrence, Detection and Reduction of Citrinin during the Fermentation of Red Fermented Rice. Int. J. Food Microbiol. 2022, 379, 109829. [Google Scholar] [CrossRef] [PubMed]
- Liu, G.Y.; Nizet, V. Color Me Bad: Microbial Pigments as Virulence Factors. Trends Microbiol. 2009, 17, 406–413. [Google Scholar] [CrossRef] [PubMed]
- Zhang, J.; Suo, Y.; Zhang, D.; Jin, F.; Zhao, H.; Shi, C. Genetic and Virulent Difference Between Pigmented and Non-Pigmented Staphylococcus Aureus. Front. Microbiol. 2018, 9, 598. [Google Scholar] [CrossRef]
- Lin, L.; Xu, J. Fungal Pigments and Their Roles Associated with Human Health. J. Fungi 2020, 6, 280. [Google Scholar] [CrossRef]

| Factor | Level | |||
|---|---|---|---|---|
| A | Temperature/°C | 24 | 27 | 30 |
| B | pH | 6 | 7 | 8 |
| C | Rotation speed/rpm | 130 | 160 | 190 |
| Serial Number | Temperature (°C) | pH | Rotation Speed (rpm) | Colour Value (U/mL) |
|---|---|---|---|---|
| 1 | 24 | 6 | 160 | 0.642 |
| 2 | 30 | 6 | 160 | 0.481 |
| 3 | 24 | 8 | 160 | 0.579 |
| 4 | 30 | 8 | 160 | 0.383 |
| 5 | 24 | 7 | 130 | 0.474 |
| 6 | 30 | 7 | 130 | 0.299 |
| 7 | 24 | 7 | 190 | 0.532 |
| 8 | 30 | 7 | 190 | 0.456 |
| 9 | 27 | 6 | 130 | 0.468 |
| 10 | 27 | 8 | 130 | 0.367 |
| 11 | 27 | 6 | 190 | 0.542 |
| 12 | 27 | 8 | 190 | 0.492 |
| 13 | 27 | 7 | 160 | 0.857 |
| 14 | 27 | 7 | 160 | 0.872 |
| 15 | 27 | 7 | 160 | 0.919 |
| 16 | 27 | 7 | 160 | 0.895 |
| 17 | 27 | 7 | 160 | 0.844 |
| Source | Sum of Squares | df | Mean Square | F-Value | p-Value Prob > F | Significance |
|---|---|---|---|---|---|---|
| Modelling Model | 0.66 | 9 | 0.074 | 102.38 | <0.0001 | significant |
| A Temperature | 0.046 | 1 | 0.046 | 64.05 | <0.0001 | |
| B pH | 0.012 | 1 | 0.012 | 16.87 | 0.0045 | |
| C Rotation speed | 0.021 | 1 | 0.021 | 29.7 | 0.001 | |
| AB | 0.0003062 | 1 | 0.0003062 | 0.42 | 0.5355 | |
| AC | 0.00245 | 1 | 0.00245 | 3.4 | 0.1079 | |
| BC | 0.0006502 | 1 | 0.0006502 | 0.9 | 0.374 | |
| A2 | 0.15 | 1 | 0.15 | 214.19 | <0.0001 | |
| B2 | 0.11 | 1 | 0.11 | 158.07 | <0.0001 | |
| C2 | 0.25 | 1 | 0.25 | 351.96 | <0.0001 | |
| Residual | 0.00505 | 7 | 0.0007215 | |||
| Lack of Fit | 0.001449 | 3 | 0.000483 | 0.54 | 0.6819 | not significant |
| Pure Error | 0.003601 | 4 | 0.0009003 | |||
| Cor Total | 0.67 | 16 | ||||
| R2 = 0.9925 | R2adj = 0.9828 | R2pred = 0.9570 | C.V.% = 4.52 | signal-to-noise ratio = 28.623 |
Disclaimer/Publisher’s Note: The statements, opinions and data contained in all publications are solely those of the individual author(s) and contributor(s) and not of MDPI and/or the editor(s). MDPI and/or the editor(s) disclaim responsibility for any injury to people or property resulting from any ideas, methods, instructions or products referred to in the content. |
© 2025 by the authors. Licensee MDPI, Basel, Switzerland. This article is an open access article distributed under the terms and conditions of the Creative Commons Attribution (CC BY) license (https://creativecommons.org/licenses/by/4.0/).
Share and Cite
Wang, J.; Yang, M.; Gao, X. Identification of a Red Pigment-Producing Strain of Arthrobacter spp. and the Stability of Its Pigments. Microorganisms 2025, 13, 2003. https://doi.org/10.3390/microorganisms13092003
Wang J, Yang M, Gao X. Identification of a Red Pigment-Producing Strain of Arthrobacter spp. and the Stability of Its Pigments. Microorganisms. 2025; 13(9):2003. https://doi.org/10.3390/microorganisms13092003
Chicago/Turabian StyleWang, Jinjun, Mingliang Yang, and Xinru Gao. 2025. "Identification of a Red Pigment-Producing Strain of Arthrobacter spp. and the Stability of Its Pigments" Microorganisms 13, no. 9: 2003. https://doi.org/10.3390/microorganisms13092003
APA StyleWang, J., Yang, M., & Gao, X. (2025). Identification of a Red Pigment-Producing Strain of Arthrobacter spp. and the Stability of Its Pigments. Microorganisms, 13(9), 2003. https://doi.org/10.3390/microorganisms13092003

